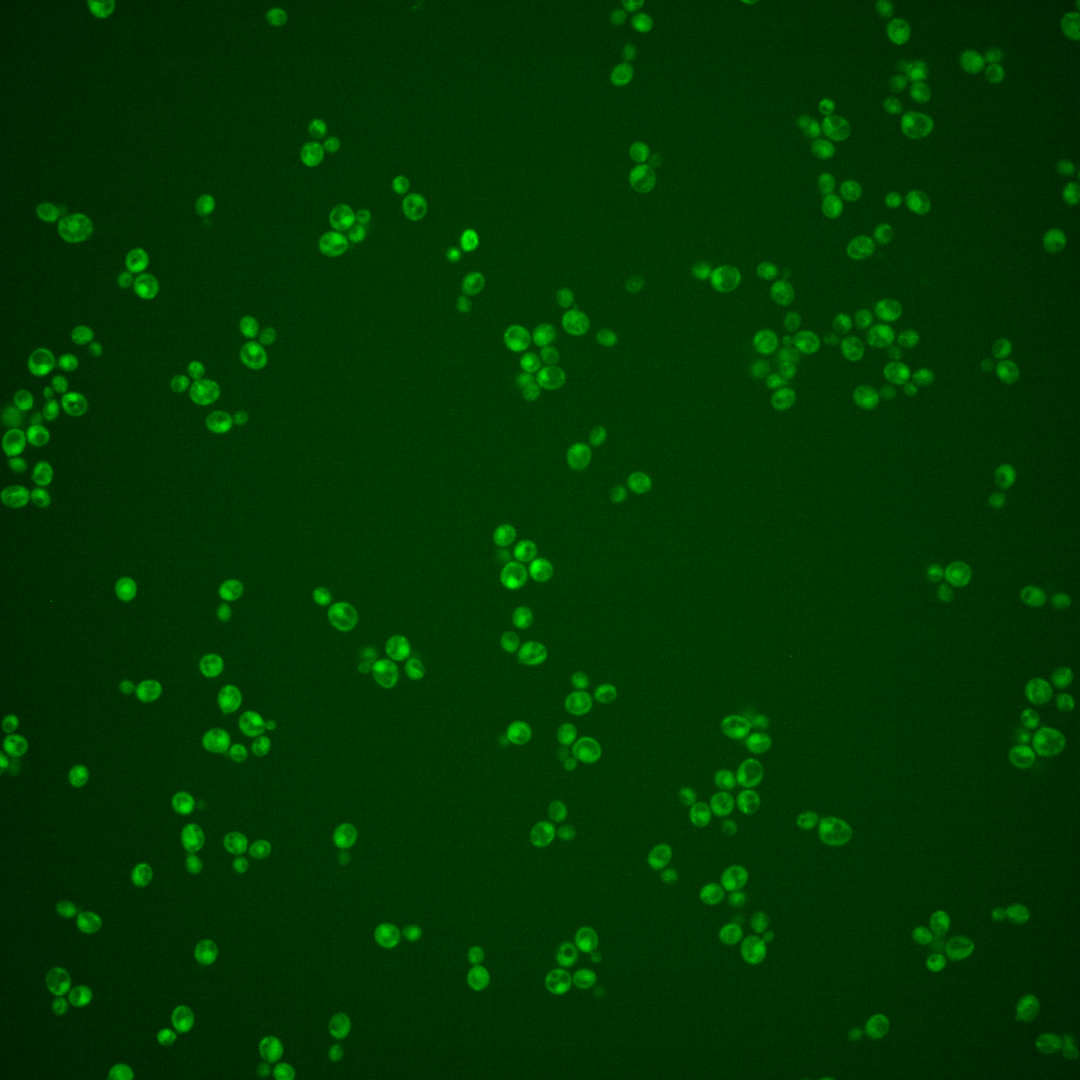

| Standard name | |
|---|---|
| Human Ortholog | |
| Description | Strand exchange protein; forms a helical filament with DNA that searches for homology; involved in the recombinational repair of double-strand breaks in DNA during vegetative growth and meiosis; homolog of Dmc1p and bacterial RecA protein |
Micrographs




















































































Sub-cellular Localization
Yeast GFP Assignment
Protein Abundance
Localization Change
External localization resources
| ensLOC | DeepLoc | |||||||||||||||||||||||
|---|---|---|---|---|---|---|---|---|---|---|---|---|---|---|---|---|---|---|---|---|---|---|---|---|
| Localization | WT1 | WT2 | WT3 | RAP60 | RAP140 | RAP220 | RAP300 | RAP380 | RAP460 | RAP540 | RAP620 | RAP700 | HU80 | HU120 | HU160 | rpd3Δ_1 | rpd3Δ_2 | rpd3Δ_3 | WT1 | WT2 | WT3 | AF100 | AF140 | AF180 |
| Cortical Patches | 0 | 0 | 0 | 0 | 0 | 0 | 0 | 0 | 0 | 0 | 0 | 0 | 0 | 0 | 1 | – | 0 | 0 | 2 | 1 | 7 | 0 | 1 | 3 |
| Bud | 2 | 0 | 0 | 3 | 4 | 4 | 17 | 9 | 9 | 9 | 10 | 2 | 0 | 0 | 2 | – | 0 | 0 | 0 | 0 | 5 | 0 | 1 | 13 |
| Bud Neck | 0 | 0 | 0 | 2 | 3 | 2 | 3 | 1 | 3 | 1 | 0 | 1 | 1 | 5 | 0 | – | 0 | 0 | 0 | 1 | 4 | 0 | 0 | 2 |
| Bud Site | 0 | 0 | 0 | 0 | 1 | 1 | 1 | 7 | 0 | 2 | 1 | 2 | 0 | 0 | 0 | – | 0 | 0 | – | – | – | – | – | – |
| Cell Periphery | 0 | 0 | 2 | 1 | 3 | 0 | 0 | 0 | 1 | 0 | 0 | 1 | 2 | 8 | 1 | – | 6 | 1 | 0 | 0 | 4 | 0 | 0 | 2 |
| Cytoplasm | 101 | 124 | 252 | 213 | 300 | 284 | 340 | 347 | 258 | 252 | 139 | 174 | 253 | 421 | 450 | – | 130 | 89 | 82 | 105 | 144 | 108 | 224 | 313 |
| Endoplasmic Reticulum | 1 | 0 | 0 | 0 | 0 | 0 | 0 | 0 | 0 | 0 | 0 | 3 | 2 | 1 | 0 | – | 7 | 7 | 4 | 0 | 2 | 0 | 2 | 1 |
| Endosome | 0 | 0 | 1 | 0 | 4 | 0 | 1 | 0 | 1 | 0 | 1 | 0 | 1 | 0 | 2 | – | 2 | 4 | 2 | 3 | 5 | 0 | 1 | 1 |
| Golgi | 0 | 0 | 1 | 1 | 0 | 0 | 0 | 0 | 0 | 0 | 0 | 0 | 1 | 0 | 0 | – | 1 | 0 | 0 | 0 | 3 | 0 | 0 | 0 |
| Mitochondria | 38 | 8 | 2 | 27 | 20 | 112 | 200 | 139 | 137 | 191 | 172 | 183 | 0 | 1 | 1 | – | 3 | 3 | 29 | 13 | 55 | 2 | 6 | 9 |
| Nucleus | 0 | 0 | 0 | 1 | 1 | 1 | 2 | 3 | 1 | 1 | 2 | 1 | 0 | 0 | 2 | – | 0 | 0 | 0 | 0 | 0 | 1 | 0 | 0 |
| Nuclear Periphery | 0 | 0 | 0 | 1 | 0 | 0 | 0 | 1 | 0 | 0 | 0 | 2 | 0 | 0 | 1 | – | 0 | 0 | 1 | 0 | 1 | 0 | 0 | 2 |
| Nucleolus | 0 | 0 | 0 | 1 | 1 | 0 | 1 | 1 | 0 | 1 | 0 | 1 | 0 | 0 | 0 | – | 1 | 0 | 0 | 0 | 0 | 0 | 0 | 1 |
| Peroxisomes | 0 | 0 | 0 | 0 | 0 | 0 | 1 | 0 | 0 | 1 | 0 | 0 | 0 | 1 | 0 | – | 1 | 0 | 1 | 0 | 0 | 0 | 0 | 0 |
| SpindlePole | 1 | 0 | 3 | 2 | 3 | 2 | 7 | 27 | 11 | 10 | 6 | 9 | 0 | 0 | 0 | – | 1 | 3 | 3 | 2 | 5 | 0 | 1 | 8 |
| Vac/Vac Membrane | 0 | 0 | 1 | 1 | 0 | 1 | 2 | 8 | 0 | 2 | 4 | 4 | 0 | 0 | 0 | – | 8 | 5 | 4 | 4 | 6 | 1 | 3 | 2 |
| Unique Cell Count | 124 | 127 | 253 | 228 | 315 | 328 | 463 | 448 | 345 | 382 | 252 | 304 | 257 | 423 | 455 | 141 | 101 | 140 | 136 | 253 | 120 | 248 | 374 | |
| Labelled Cell Count | 143 | 132 | 262 | 253 | 340 | 407 | 575 | 543 | 421 | 470 | 335 | 383 | 260 | 437 | 460 | 160 | 112 | 140 | 136 | 253 | 120 | 248 | 374 | |
Yeast GFP Assignment
Protein Abundance
| Screen | WT1 | WT2 | WT3 | RAP60 | RAP140 | RAP220 | RAP300 | RAP380 | RAP460 | RAP540 | RAP620 | RAP700 | HU80 | HU120 | HU160 | rpd3Δ_1 | rpd3Δ_2 | rpd3Δ_3 | AF100 | AF140 | AF180 |
|---|---|---|---|---|---|---|---|---|---|---|---|---|---|---|---|---|---|---|---|---|---|
| Mean Cell GFP Intensity (1e-4) | 3.1 | 3.9 | 4.1 | 3.4 | 3.7 | 3.0 | 3.0 | 3.0 | 2.8 | 2.7 | 2.5 | 2.5 | 4.7 | 4.7 | 4.8 | 4.8 | 5.1 | 5.8 | 4.2 | 4.8 | 5.4 |
| Std Deviation (1e-4) | 0.6 | 0.9 | 4.5 | 1.5 | 1.7 | 1.2 | 1.6 | 1.8 | 1.4 | 1.2 | 1.3 | 1.2 | 1.0 | 1.2 | 1.2 | 1.3 | 1.5 | 2.6 | 1.3 | 1.2 | 1.4 |
| Intensity Change (Log2) | – | – | – | -0.25 | -0.15 | -0.45 | -0.46 | -0.43 | -0.55 | -0.59 | -0.69 | -0.7 | 0.22 | 0.2 | 0.22 | 0.23 | 0.33 | 0.51 | 0.04 | 0.24 | 0.4 |
Localization Change
| Localization | RAP60 | RAP140 | RAP220 | RAP300 | RAP380 | RAP460 | RAP540 | RAP620 | RAP700 | HU80 | HU120 | HU160 | rpd3Δ_1 | rpd3Δ_2 | rpd3Δ_3 |
|---|---|---|---|---|---|---|---|---|---|---|---|---|---|---|---|
| Actin | – | – | – | – | – | – | – | – | – | – | – | – | – | – | – |
| Bud | – | – | – | – | – | – | – | – | – | – | – | – | – | – | – |
| Bud Neck | – | – | – | – | – | – | – | – | – | – | – | – | – | – | – |
| Bud Site | – | – | – | – | – | – | – | – | – | – | – | – | – | – | – |
| Cell Periphery | – | – | – | – | – | – | – | – | – | – | – | – | – | – | – |
| Cyto | – | – | – | – | – | – | – | – | – | – | – | – | – | – | – |
| Endoplasmic Reticulum | – | – | – | – | – | – | – | – | – | – | – | – | – | – | – |
| Endosome | – | – | – | – | – | – | – | – | – | – | – | – | – | – | – |
| Golgi | – | – | – | – | – | – | – | – | – | – | – | – | – | – | – |
| Mitochondria | – | – | – | – | – | – | – | – | – | – | – | – | – | – | – |
| Nuclear Periphery | – | – | – | – | – | – | – | – | – | – | – | – | – | – | – |
| Nuc | – | – | – | – | – | – | – | – | – | – | – | – | – | – | – |
| Nucleolus | – | – | – | – | – | – | – | – | – | – | – | – | – | – | – |
| Peroxisomes | – | – | – | – | – | – | – | – | – | – | – | – | – | – | – |
| SpindlePole | – | – | – | – | – | – | – | – | – | – | – | – | – | – | – |
| Vac | – | – | – | – | – | – | – | – | – | – | – | – | – | – | – |
| Cortical Patches | – | – | – | – | – | – | – | – | – | – | – | – | – | – | – |
| Cytoplasm | – | – | – | – | – | – | – | – | – | – | – | – | – | – | – |
| Nucleus | – | – | – | – | – | – | – | – | – | – | – | – | – | – | – |
| Vacuole | – | – | – | – | – | – | – | – | – | – | – | – | – | – | – |
External localization resources
Images






























Protein Concentration and Protein Localization Data
| R1 | R2 | R3 | ||||||||||||||||
|---|---|---|---|---|---|---|---|---|---|---|---|---|---|---|---|---|---|---|
| G1 Pre-START | G1 Post-START | S/G2 | Metaphase | Anaphase | Telophase | G1 Pre-START | G1 Post-START | S/G2 | Metaphase | Anaphase | Telophase | G1 Pre-START | G1 Post-START | S/G2 | Metaphase | Anaphase | Telophase | |
| Concentration | 0.0044 | -0.1159 | -0.1075 | -0.1758 | 0.2166 | -0.2047 | -0.9682 | -1.1017 | -1.1536 | -1.2062 | -1.4337 | -1.1115 | -2.5534 | -2.0506 | -2.5875 | -1.9923 | -1.9825 | -2.2357 |
| Actin | 0.0467 | 0.0005 | 0.0139 | 0.0001 | 0.0455 | 0.0073 | 0.0338 | 0.0034 | 0.0165 | 0.0001 | 0.0007 | 0.0182 | 0.0082 | 0.0015 | 0.002 | 0.0001 | 0.0196 | 0.0034 |
| Bud | 0.0014 | 0.0009 | 0.0019 | 0 | 0.0003 | 0.0001 | 0.002 | 0.0109 | 0.0007 | 0.0001 | 0.0001 | 0.001 | 0.0021 | 0.0047 | 0.0002 | 0.0001 | 0.001 | 0.0001 |
| Bud Neck | 0.0032 | 0.0004 | 0.0015 | 0 | 0.0022 | 0.0001 | 0.0033 | 0.0002 | 0.0007 | 0.0001 | 0.0001 | 0.0007 | 0.0009 | 0.0001 | 0 | 0 | 0.0002 | 0.0001 |
| Bud Periphery | 0.0029 | 0.0008 | 0.0047 | 0.0001 | 0.0006 | 0.0004 | 0.0078 | 0.0146 | 0.001 | 0 | 0.0001 | 0.004 | 0.0017 | 0.0039 | 0.0001 | 0.0001 | 0.0015 | 0.0001 |
| Bud Site | 0.0056 | 0.0125 | 0.0069 | 0 | 0.0013 | 0 | 0.0098 | 0.0157 | 0.008 | 0.0002 | 0.0005 | 0.0005 | 0.0111 | 0.0019 | 0.0002 | 0 | 0.0004 | 0.0002 |
| Cell Periphery | 0.0004 | 0.0002 | 0.0005 | 0 | 0.0003 | 0 | 0.0004 | 0.0004 | 0.0001 | 0 | 0 | 0.0001 | 0.0003 | 0.0002 | 0 | 0 | 0.0001 | 0 |
| Cytoplasm | 0.0181 | 0.0298 | 0.017 | 0.0201 | 0.0479 | 0.025 | 0.0525 | 0.114 | 0.1031 | 0.1675 | 0.1057 | 0.1584 | 0.0274 | 0.0365 | 0.0387 | 0.0209 | 0.0272 | 0.0618 |
| Cytoplasmic Foci | 0.0199 | 0.0027 | 0.0124 | 0.0019 | 0.0077 | 0.005 | 0.0456 | 0.0119 | 0.008 | 0.0056 | 0.0251 | 0.0128 | 0.0217 | 0.0124 | 0.0069 | 0.0088 | 0.0661 | 0.0091 |
| Eisosomes | 0.0006 | 0.0002 | 0.0047 | 0.0002 | 0.0006 | 0.0001 | 0.0004 | 0.0002 | 0.0002 | 0.0001 | 0 | 0.0001 | 0.0003 | 0.0001 | 0.0001 | 0.0001 | 0.0003 | 0.0001 |
| Endoplasmic Reticulum | 0.0033 | 0.0004 | 0.0008 | 0.0001 | 0.0032 | 0.0003 | 0.0048 | 0.0013 | 0.0008 | 0.001 | 0.0013 | 0.0016 | 0.0046 | 0.0009 | 0.0004 | 0.0003 | 0.0014 | 0.0005 |
| Endosome | 0.0095 | 0.0028 | 0.0041 | 0.0001 | 0.04 | 0.0008 | 0.0531 | 0.002 | 0.0017 | 0.0352 | 0.0062 | 0.0123 | 0.0107 | 0.0014 | 0.0005 | 0.0007 | 0.0043 | 0.0085 |
| Golgi | 0.0053 | 0.0001 | 0.0021 | 0 | 0.0261 | 0.0009 | 0.0143 | 0.0007 | 0.0023 | 0.0009 | 0.0043 | 0.0094 | 0.0026 | 0.0007 | 0.0007 | 0.0001 | 0.0062 | 0.0033 |
| Lipid Particles | 0.0093 | 0.0002 | 0.0064 | 0.0001 | 0.022 | 0.0016 | 0.0518 | 0.0007 | 0.0052 | 0.0001 | 0.0101 | 0.0075 | 0.0063 | 0.0043 | 0.0035 | 0.0003 | 0.0211 | 0.007 |
| Mitochondria | 0.0075 | 0.0004 | 0.0027 | 0.0001 | 0.0097 | 0.0003 | 0.0119 | 0.0065 | 0.0103 | 0.0003 | 0.0009 | 0.0173 | 0.0031 | 0.0015 | 0.0034 | 0.0005 | 0.0075 | 0.0021 |
| None | 0.8357 | 0.9363 | 0.8967 | 0.9767 | 0.7575 | 0.9551 | 0.6246 | 0.8118 | 0.833 | 0.7807 | 0.8294 | 0.7395 | 0.8594 | 0.9221 | 0.9387 | 0.9583 | 0.7744 | 0.9003 |
| Nuclear Periphery | 0.0043 | 0.0007 | 0.0019 | 0.0001 | 0.0084 | 0.0005 | 0.01 | 0.0008 | 0.0005 | 0.0008 | 0.0005 | 0.0036 | 0.0193 | 0.0003 | 0.0004 | 0.0003 | 0.0009 | 0.0006 |
| Nucleolus | 0.0014 | 0.0008 | 0.0018 | 0 | 0.0009 | 0.0001 | 0.0048 | 0.0005 | 0.0001 | 0 | 0.0001 | 0.0005 | 0.0018 | 0.0002 | 0.0003 | 0.0003 | 0.0001 | 0 |
| Nucleus | 0.0027 | 0.0022 | 0.0026 | 0.0001 | 0.0017 | 0.0003 | 0.0034 | 0.0008 | 0.0003 | 0.0006 | 0.0005 | 0.0019 | 0.0088 | 0.0013 | 0.0005 | 0.0004 | 0.0003 | 0.0002 |
| Peroxisomes | 0.0154 | 0.0002 | 0.0083 | 0.0001 | 0.0137 | 0.0009 | 0.0138 | 0.0005 | 0.006 | 0.0001 | 0.0113 | 0.0031 | 0.0031 | 0.0044 | 0.0008 | 0.0001 | 0.065 | 0.0009 |
| Punctate Nuclear | 0.0051 | 0.0018 | 0.0074 | 0.0001 | 0.004 | 0.001 | 0.0394 | 0.0017 | 0.0009 | 0.0002 | 0.0019 | 0.004 | 0.0042 | 0.0006 | 0.0021 | 0.0077 | 0.0011 | 0.0004 |
| Vacuole | 0.0011 | 0.0048 | 0.0013 | 0.0001 | 0.0032 | 0.0001 | 0.0086 | 0.0009 | 0.0003 | 0.0049 | 0.001 | 0.0027 | 0.0015 | 0.0008 | 0.0002 | 0.0009 | 0.0009 | 0.001 |
| Vacuole Periphery | 0.0006 | 0.0012 | 0.0004 | 0 | 0.0031 | 0 | 0.004 | 0.0003 | 0.0002 | 0.0014 | 0.0002 | 0.0009 | 0.001 | 0.0001 | 0.0001 | 0.0002 | 0.0005 | 0.0004 |
Sequencing Data
| R1 | R2 | |||||||||
|---|---|---|---|---|---|---|---|---|---|---|
| G1 Post-START | S/G2 | Metaphase | Anaphase | Telophase | G1 Post-START | S/G2 | Metaphase | Anaphase | Telophase | |
| Gene Expression | 77.0457 | 40.9965 | 21.2948 | 31.5605 | 88.0011 | 78.8364 | 26.3217 | 21.2625 | 34.3188 | 58.5162 |
| Translational Efficiency | 1.9056 | 1.3416 | 1.31 | 2.3257 | 1.2932 | 2.201 | 1.9275 | 1.8439 | 1.4428 | 1.698 |
Hit Data
| Dataset | Hit |
|---|---|
| Protein Concentration | ✘ |
| Protein Localization | ✘ |
| Gene Expression | ✔ |
| Translational Efficiency | ✘ |
Endocytosis
| Temp | Actin Patch (Sac6-tdTomato) | Cortical Patch (Sla1-GFP) | Late Endosome (Snf7-GFP) | Vacuole (Vph1-GFP) |
|---|---|---|---|---|
| 37℃ | ||||
| RT |
Cell Cycle Omics
CYCLoPs (Rad51-GFP)
| Gene / Allele | Actin Patch (Sac6-tdTomato) | Cortical Patch (Sla1-GFP) | Late Endosome (Snf7-GFP) | Vacuole (Sac6-tdTomato) |
|---|
| Gene | Images |
|---|
| Gene | Images |
|---|
Images are not yet available
Images are not yet available